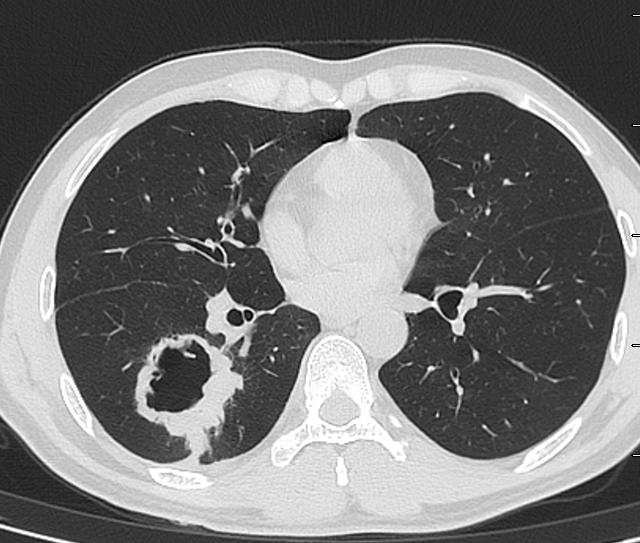
肺脓肿导管引流,肺脓肿的引流管脱落怎么办
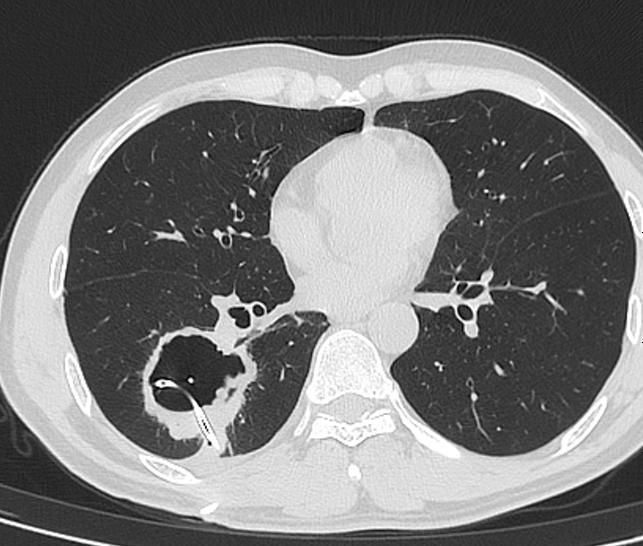
肺脓肿导管引流,肺脓肿的引流管脱落怎么办

肺脓肿经皮穿刺引流不是肺脓肿的首选治疗
前言
肺脓肿首选抗生素治疗,但是,很多人就喜欢骚操作,想着放个引流管进去把脓液引流出来就可以达到“立竿见影”的效果!
殊不知,肺脓肿经皮穿刺引流不是肺脓肿的首选治疗,这个操作涉及到很多医学知识,要有足够的专业知识来权衡利弊才能操作,千万不要随便搞。
为什么这么说呢?给大家分享一个啼笑皆非的病例,各位小伙伴就明白了。
1
经典的神奇病例
中年人,咳嗽咳痰约3月。
没有发热,没有大量脓痰,没有心率加快,没虚弱无力,能吃能动,没有营养不良。
CT发现右肺下叶一大个空洞。
图01
外院不知道为什么就考虑肺脓肿,还在“脓腔”里面放一大个引流管。这种骚操作,不容易见到。各位请看。

图02-05
首先,我们不得不承认,这个放引流管的水平,确实高!就像洲际导弹,准确的命中目标,引流管放在了空洞的正中央。
但是,秀操作需要专业的医学知识!杀猪的做阑尾炎手术肯定比刚毕业的研究生厉害,但是他们做不了医生,因为没有深厚的医学功底。
这个空洞,是个典型的肺鳞癌。根本就没有必要放个引流管。
首先,患者没有明显的感染症状!其次,这个空洞没有气液平,也不像肺脓肿。最后,这个空洞乱糟糟的,有些地方壁厚,有些地方壁薄,空洞里面凹凸不平,空洞周围边界清晰,没有炎症反应引起的模糊阴影。外加患者是中年人,基本上就是肺鳞癌。
肺鳞癌放个大管子,没有用,极少数情况下,还可能导致肿瘤播散。
那这个患者后来如何呢?
这个引流管放进去,啥都没有引流出来,还导致了少量气胸。

图06
患者转我院,手术切除空洞,病例:肺鳞癌。
2
肺脓肿能不能放引流管?
肺脓肿是可以放引流管的,前提是抗生素治疗效果不好,一般首选在支气管镜引导下,经气道放置引流管,这样子可以避免支气管胸膜瘘。
CT引导下经皮放置引流管,也可以,但是,你首先要知道什么是支气管胸膜瘘。
支气管胸膜瘘:支气管与胸膜相通,可能会导致无穷无尽的气胸。
CT引导下穿刺,经皮在肺脓肿里面放置引流管,可能会导致支气管胸膜瘘,患者本身有感染,瘘口可能不容易长好,结果就是无穷无尽的气胸!
有学者做过meta分析,26项研究纳入分析,194例患者,17例(8.8%)发生严重的并发症,其中支气管胸膜瘘5例(2.6%),4例(2.1%)死亡。
并发支气管胸膜瘘的可能性不小。
除非不得已,要不然,肺脓肿不要随便放引流管。
3
大多数肺脓肿不需要放置引流管
大多数的肺脓肿,使用抗生素就能搞定,不需要穿刺引流。有研究显示,抗生素的有效率在80%~90%左右。
有研究显示,肺脓肿穿刺引流的成功率,不同的研究结果不同,波动在55%~100%之间。
在现实临床上,大多数的患者,也没有选择穿刺引流治疗肺脓肿。
国内有学者做过肺脓肿穿刺引流的mete分析,纳入了85篇文献,居然所有研究均来自于中国,这个真不好说。
国外有学者做过meta分析(穿刺引流肺脓肿),26项研究纳入分析,居然只有194例患者纳入研究,说明绝大多数的医生不选择这种办法。
4
肺脓肿穿刺引流的案例
抗生素治疗效果实在不好,患者及家属非常理解穿刺引流的好处和风险,也可以考虑穿刺引流。
例1
老年男性,抗生素治疗失败。CT示右下叶一大个脓腔。

图07
脓肿穿刺,放置引流管,3周后完全愈合。

图08
例2
26岁女性,肺脓肿,抗生素治疗1周,仍然发热。
CT引导下,肺脓肿穿刺引流(下图B、C),术后随访,脓液完全引出(下图D)。

图09
例3
42岁男性,发热,肺脓肿。
美罗培南和万古霉素进行抗生素治疗。持续5天的抗生素治疗,没有显示出令人满意的临床结果。

图10
估计又是熟悉的一幕:家属天天追着医生念紧箍咒“怎么还在发热?”“你们医生有没有责任心?”“有没有良心?”
怎么办?
在CT引导下,在肺脓肿里面放入10Fr猪尾导管,然后引流肺脓肿。然而,只排出42毫升脓液。患者仍然发热,肺部的病灶还增多了。

图11
后来如何?
后来引流管就再也没有脓液出来,患者病情加重,呼吸衰竭,气管插管,上呼吸机!
怎么办?
换大号引流管,直接上28Fr猪尾导管,是以前的大约3倍。
患者上着呼吸机,搞个全麻,双腔管单肺通气,隔离左肺(防止脓液进入),在X线引导下放入大号引流管。

图12
结果如何?
负10cmH2O的压力吸引,8天引流出650毫升脓液,脓液检测到口腔普氏杆菌、血管链球菌和坏死梭杆菌,抗生素治疗降级为舒巴坦钠/氨苄西林钠,5天后脱离呼吸机,第18天取出导管,40天后出院。
7个月后,他的胸部CT证实肺脓肿完全治愈,但遗留了一个薄壁空洞。
小结:
肺脓肿不要随意穿刺放引流管,术前要充分的评估。
不要见到空洞就秀操作,别人没有秀操作,可能是因为别人经验丰富,老司机不随便飙车。
家属理解且同意,难治性肺脓肿也可以放置引流管。
参考文献:
[1]Oh M,et al.Effective exchange to a larger size catheter for a lung abscess with initial percutaneous drainage failure:a case report.Surg Case Rep.2020.
[2]Kelogrigoris M,et al.CT-guided percutaneous drainage of lung abscesses:review of 40 cases.JBR-BTR.2011.
[3]Lee JH,et al.Percutaneous transthoracic catheter drainage for lung abscess:a systematic review and meta-analysis.Eur Radiol.2022.
[4]林琪斌.肺脓肿抗生素及介入引流治疗的相关研究[D].温州医科大学,2020.
[5]Kelogrigoris M,et al.CT-guided percutaneous drainage of lung abscesses:review of 40 cases.JBR-BTR.2011.
本文首发:医学界呼吸频道
本文作者:孙丹雄
【版权声明】本平台属公益学习平台,转载系出于传递更多学习信息之目的,且已标明作者和出处,如不希望被传播的老师可与我们联系删除